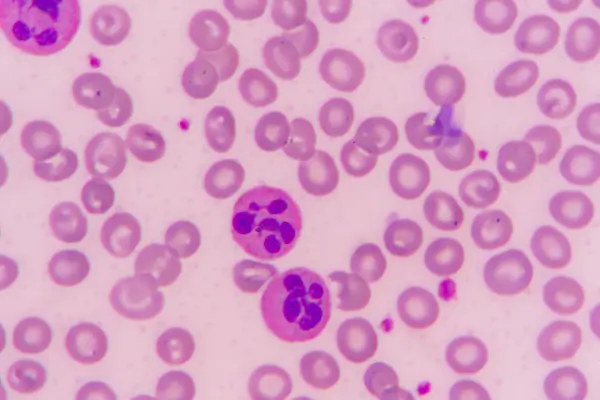

Clinical Evaluation for Neurovascular Guide Catheters
Celegence Deploys Centre of Excellence Model to Streamline Regulatory Activities
Project Summary
A global biopharmaceutical company headquartered in France wanted to streamline operations for its regulatory affairs activities, including xEVMPD submissions, document formatting, publishing and submissions to health authorities, and RIMS data collection and management.
To achieve these objectives, the company needed to overcome several challenges. First, its limited internal resources were required to manage regulatory, pharmacovigilance and medical affairs activities. A second big issue was that of consistency, both in terms of RIMS data and in terms of MS-Word templates for dossier submissions. A third big challenge for the company was addressing the competing priorities between regulatory data management and regulatory operations in terms of pre-submission, submission and post-submission activities.
Celegence Solution & Approach:
The biopharma client chose Celegence and its Center of Excellence (CoE) working model was contracted to act as an extended arm of its internal regulatory affairs team. The use of the CoE model allowed for integrated teams to be built, creating synergies between various regulatory activities. The Celegence team first sought to understand the current processes through multiple workshops on the different operational areas. The workshop helped the team to develop an analysis of current vs. desired outcomes and processes. Discussion focused on Standard Operating Procedures (SOPs), Work Instructions (WI), and IT tools for performing activities related to various processes as well as roles and responsibilities of the resources. This analysis helped to identify gaps in each area and to establish the optimized processes, tools and roles. Subsequently, a proof-of-concept was conducted for each process area to evaluate the effectiveness of the newly enhanced processes.
Project Achievements
Across all RA activities, Celegence helped the client achieve its objectives and improve processes. To start with, standard formatting instructions were developed for consistency in dossier submissions, including look and feel aspects of the documents. This helped to ensure that every submission would be successful with minimum rework required in the future. The Celegence team also established a roadmap for RIMS data collection from local affiliates, expanding overall process to cover global regions and business units. This has helped to ensure consistency in how RIMS data is collected across all markets. To ensure xEVMPD compliance was achieved, Celegence first addressed the backlog and then committed experienced resources to manage ongoing submissions. Celegence has put in place an experienced eCTD publishing team to manage publishing, submission and archival activities for various regions, thereby reducing burden of the client’s internal resources.
Performance measurement through KPIs combined with budget control
Process consultancy and operational improvements for the overall program, leading to overall time reduction for operations by 50%
100% quality & timeline delivery performance despite tight timelines, an achievement that would not have been possible without Celegence’s expertise
Reduction in total cost of ownership including resources, tools and other operational cost
Improved compliance based on guidance from Celegence’s regulatory experts
Find out more information
on Celegence’s Regulatory Operations Management & eCTD Publishing.
Learn MoreOther Related Articles

02 Feb, 2026
Contact Us Today
From document publishing automation to eCTD submissions and beyond, Celegence is your trusted partner for regulatory affairs excellence. Contact us to learn how we can help you achieve your compliance goals efficiently and cost-effectively.
* indicates required fields







